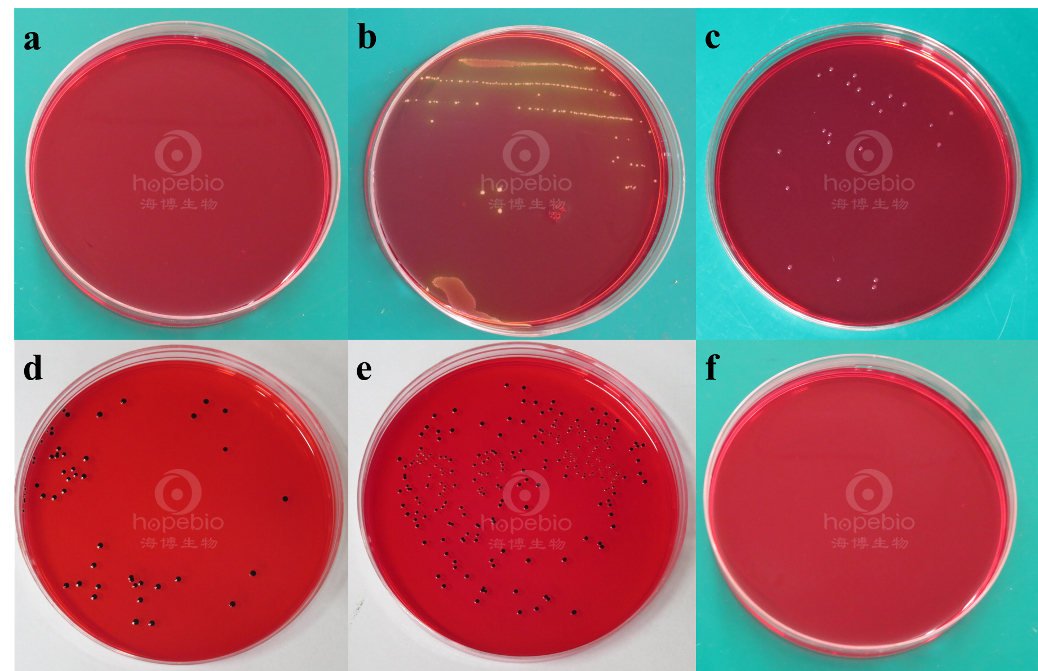
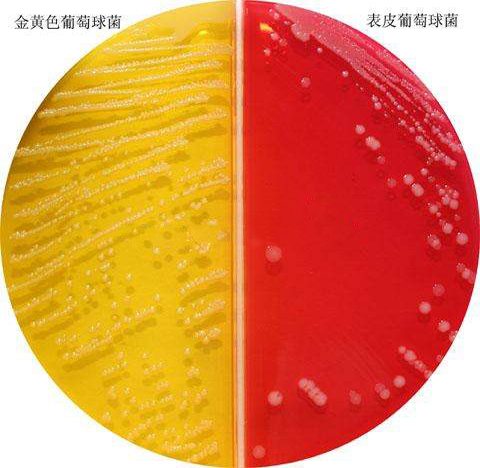
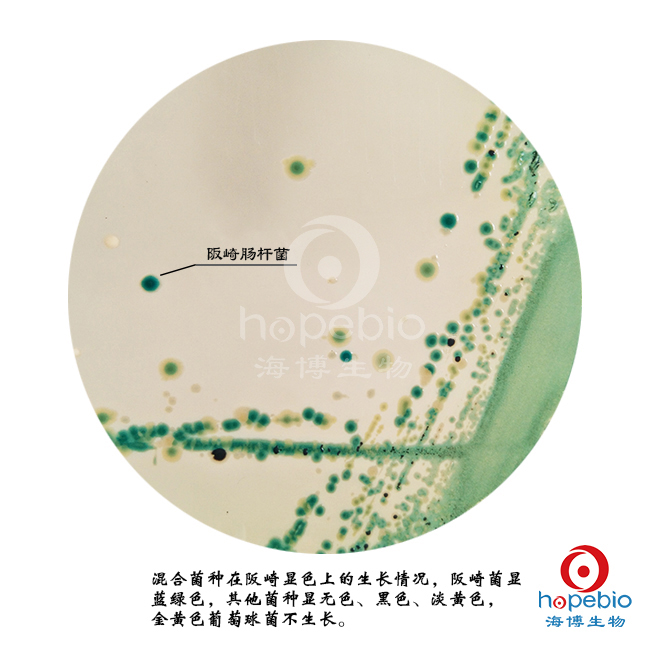

海博微信公众号
海博微信公众号
 海博天猫旗舰店
海博天猫旗舰店


 海博微信公众号
海博微信公众号
 海博天猫旗舰店
海博天猫旗舰店




微生物培养,在选择性分离培养基、显色培养基上的菌落特征,皆由微生物生长繁殖及代谢产物决定,培养基所含营养物质,皆为了满足微生物生长和代谢所需。
一、培养基简介:
培养基是供微生物、植物和动物组织生长和维持用的人工配制的养料,一般都含有碳水化合物、含氮物质、无机盐(包括微量元素)以及维生素和水等。有的培养基还含有抗菌素和色素,用于各种微生物培养和鉴定。
一般基础培养基中含有蛋白胨、牛肉浸粉、酵母浸膏、氯化钠、琼脂等基本营养万分。
一些选择、鉴定培养基根据用途不同,则需加入抑菌剂、指示剂、血液、糖等试剂,以利于需要菌的生长与鉴别。
一些需要使细菌大量生长、繁殖的培养基,主要成分多为氨基酸、核苷酸、无机盐、生长因子等。
琼脂:是由石花菜或江篱(属红藻)中提取的一种藻胶,是由琼脂糖和琼胶质组成的长链多糖化合物。优点在于不能被细菌分解利用,在细菌培养的温度下凝胶强度稳定。
蛋白胨:为动物蛋白经酶消化后产物,能为微生物提供C源、N源、生长因子等营养物质。
胰酪蛋白胨:是一种优质蛋白胨,亦称胰酶消化酪蛋白胨或胰蛋白胨。系采用酪蛋白经胰酶消化后,浓缩干燥而成。可配制各种微生物培养基,用于细菌的培养、分离、增殖、鉴定,以及无菌试验培养基、厌氧菌培养基等细菌生化特性试验用培养基的配置。
牛肉浸膏:是新鲜牛肉经剔除脂肪,消化过滤浓缩得到的一种营养物质,含有肌酸、肌酸酐、多肽类、氨基酸、核苷酸、有机酸、矿物质及维生素的水溶性物质。主要作用是为了补充蛋白胨以及其他氮源的营养不足。
酵母粉:富含B族维生素、有机氮以及碳水化合物等营养物质。
胆盐:是胆酸钠盐,是从动物的胆汁中提取的一种混合物,含胆酸、结合胆酸以及胆汁醇等,胆盐用在培养基中是作为选择性抑制剂,主要抑制革兰氏阳性菌的生长。
二、培养基分类:
按营养物质可分为:
1、天然培养基:指一类利用动、植物或微生物体包括其提取物制成的培养基。如牛肉膏蛋白胨培养基、麦芽汁培养基等。
2、组合培养基:又称为合成培养基或综合培养基,是一类按微生物的营养要求精确设计后用多种高纯化学试剂配制成的培养基。如葡萄糖铵盐培养基、淀粉硝酸盐培养基等。
3、半组合培养基:一类主要以化学试剂配制,同时还加有某种或某些天然成分的培养基。例如,马铃薯蔗糖培养基。
按物理性状分:
1、液体培养基:一类呈液态的培养基。
2、固体培养基:一类外观呈固态的培养基。根据性质又分为。固化培养基、非可逆性固化培养基、天然固态培养基、滤膜。
3、半固体培养基:指在液体培养基中加入少量的凝固剂而配制成的半固体状态的培养基。
4、脱水培养基:又称预制干燥培养基,指含有除水分外的一切成分的商品培养基。
按功能性分为:
1、选择性培养基:一类根据某微生物的特殊营养要求或其对某化学、物理因素的抗性而设计的培养基,具有使混合菌样中的劣势菌变成优势菌的功能,广泛用于菌种筛选等领域。
2、鉴别培养基:一类在成分中加有能与目的菌的无色代谢产物发生显色反应的指示剂,从而达到只须用肉眼辨别颜色就能方便的从近似菌落中找出目的菌菌落的培养基。例如,伊红美蓝乳糖培养基(EMB)。
3、运输培养基
4、保存培养基
5、复苏培养基
6、增菌培养基
7、鉴定培养基
8、多用途培养基
三、培养基常用指示剂及变色范围:

四、几种ISO、GB、SN常见选择性培养基及显色培养基的培养基配方及菌落特征分析:
大肠杆菌在结晶紫中性红胆盐琼脂(VRBA)上的菌落特征
结晶紫中性红胆盐琼脂(VRBA)
成分(g/L):
蛋白胨 7.0
酵母粉 3.0
氯化钠 5.0
乳糖 10.0
胆盐 1.5
结晶紫 0.002
中性红 0.03
琼脂 15.0
pH值7.4 ± 0.1 25℃
用法:
称取本品 41.5g,加热溶解于1000ml 蒸馏水中,煮沸不要超过2 分钟。取适宜稀释度样品液 1ml,加入到无菌平皿中心,将冷至 45 ± 0.5℃ 的 VRBA 10-15ml倾注于平皿中。小心旋转平皿将培养基与样液充分混匀。凝固后,再加 3-4ml VRBA 覆盖平板表层 ,翻转平板 ,置于36 ± 1℃培养 18-24 小时。无需高压灭菌。临用时制备,不得超过3 小时。
检验原理:
蛋白胨和酵母浸粉提供碳氮源、维生素、生长因子和辅酶等其他营养物质;氯化钠维持均衡的渗透;乳糖为可发酵碳水化合物,可作为一种能量来源;3 号胆盐和结晶紫可抑制革兰氏阳性菌的生长;中性红为指示剂;琼脂是培养基的凝固剂。
微生物灵敏度:
接种以下质控菌株,放置36±1℃需氧培养18-24 小时。

典型特征:
大肠埃希氏菌在结晶紫中性红胆盐琼脂(VRBA)上呈紫红色菌落,可有沉淀环。

沙门氏菌在木糖赖氨酸脱氧胆酸琼脂(XLD)上的菌落特征
木糖赖氨酸脱氧胆酸琼脂(XLD)
成分(g/L):
酵母浸粉 3.0
L-赖氨酸 5.0
乳糖 7.5
蔗糖 7.5
木糖 3.75
氯化钠 5.0
硫代硫酸钠 6.8
柠檬酸铁铵 0.8
去氧胆酸盐 2.5
苯酚红 0.08
琼脂 15.0
pH值7.4 ± 0.2 25℃
用法:
称取本品 57g,加热搅拌溶解于 1000ml 蒸馏水中,不要过分加热,冷至 50-55℃时,倾入无菌平皿,部分开盖干燥 2h,然后盖上,备用。无需高压灭菌。在 24小时内使用。
检验原理:
酵母浸粉提供氮源、维生素、生长因子; 氯化钠维持均衡的渗透压;木塘、乳糖、蔗糖为可发酵糖类,产酸使苯酚红指示剂变黄;去氧胆酸钠抑制革兰氏阳性菌,但不影响沙门氏菌的生长;硫代硫酸钠可被某些细菌还原硫化氢,与柠檬酸铁铵中的铁盐生成黑色硫化铁;琼脂是培养基的凝固剂;苯酚红为pH指示剂。
微生物灵敏度:
接种以下质控菌株,放置36±1℃需氧培养18-24 小时。
典型特征:
木糖赖氨酸脱氧胆酸琼脂(XLD)中的酵母粉为细菌生长提供维生素和辅助因子,木糖、乳糖和蔗糖作为可发酵的碳源。除志贺菌外,其他大多数肠杆菌均发酵木糖,加入的赖氨酸是为了鉴别沙门氏菌。沙门发酵木糖产酸,形成酸性环境有利于该菌产生脱羧酶,从而使培养基的pH升高向碱性转变,但可因其他菌发酵乳糖和蔗糖产生大量的酸而中和,在碱性条件下,硫代硫酸钠及柠檬酸铁铵与沙门菌产生的硫代氢反应使菌落颜色呈黑色,酸性条件下下反应被抑制。酚红作为指示剂,NaCl维持培养基渗透压,去氧胆盐钠抑制一般革兰阳性菌生长,也可抑制大肠杆菌生长。。根据ISO和GB、FDA BAM方法,沙门菌在木糖赖氨酸脱氧胆酸琼脂(XLD)大多数可形成红色带黑心的菌落,约为2mm,光滑、湿润、边缘整齐。
备注:a:金黄色葡萄球菌 b:大肠埃希氏菌 c:福氏志贺氏菌 d:鼠伤寒沙门氏菌 e:肠炎沙门氏菌 f: 空白对照
金黄色葡萄球菌在甘露醇高盐琼脂上的菌落特征:
甘露醇高盐琼脂
成分(g/L):
蛋白胨 10.0
牛肉粉 1.0
D-甘露醇 10.0
氯化钠 75.0
酚红 0.025
琼脂 13.0
pH值7.4 ± 0.2 25℃
用法:
称取本品 109.0g,加入 1000ml蒸馏水中,加热溶解并不停搅拌煮沸 1 分钟。121℃高压灭菌15 分钟,冷至 45-50℃左右时,倾入无菌平皿。
微生物灵敏度:
接种以下质控菌株,放置36±1℃需氧培养18-24 小时。

典型特征:
甘露醇高盐琼脂中的NaCl能够抑制不耐盐的非葡萄球菌生长,D-甘露醇为碳源,酚红指示剂,凝固酶阳性菌能利用D-甘露醇产酸使酚红由红色变黄色。
阪崎肠杆菌在阪崎肠杆菌显色培养基上的菌落特征
阪崎肠杆菌显色培养基
成分(g/L):
胰蛋白胨 15.0g
大豆蛋白胨 5.0g
氯化钠 5.0g
柠檬酸铁按 1.0g
硫代硫酸钠 1.0g
脱氧胆酸钠 1.0g
5-溴-4-氯-3-吲哚-α-D-吡喃葡萄糖 0.1g
琼脂 15g
蒸馏水 1000mL
pH 7.3±0.2 25℃
操作步骤:
1、用接种环接种mLST-Vm肉汤或EE肉汤增菌液10µl划线或涂布于阪崎肠杆菌显色平板上;
2、倒置放入培养箱36±1℃培养22-26h,典型的阪崎肠杆菌为蓝-绿色菌落;
3、挑取典型菌落做生化试验。
微生物灵敏度:
接种以下质控菌株,放置36±1℃需氧培养18-24 小时。
典型特征:
典型的阪崎肠杆菌为蓝-绿色菌落,其它菌为无色、乳白色、黄色、黑色菌落。
阪崎肠杆菌生长代谢时产生葡萄糖苷酶,与培养基中经过酶切释放出显色基团,使菌体呈蓝绿色菌落。
下一篇:几种常用的灭菌方法汇总



